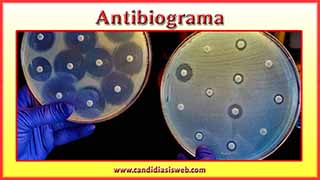
Antibiograma

El selenio es un micromineral con importantes funciones metabólicas como la prevención del daño celular provocada por los radicales libres, la regulación de la glándula tiroides o la potenciación del sistema inmune, entre otras.

La candidiasis crónica puede ser la causante, tanto de forma directa como indirecta, de un gran número de trastornos así como generar un cuadro de síntomas muy extenso y confuso.

La bacteriemia es la presencia de bacterias en el torrente sanguíneo, lo que puede dar lugar a la aparición de abscesos, peritonitis, endocarditis o meningitis.

La histoplasmosis es una infección causada por la inhalación de las esporas del hongo Histoplasma capsulatum, que suele afectar a personas con el sistema inmune debilitado.
El antibiograma es una prueba microbiológica que se realiza en un laboratorio para determinar la sensibilidad o resistencia de una bacteria a un grupo de antibióticos con el fin de decidir el tratamiento adecuado para dicha cepa de bacterias.